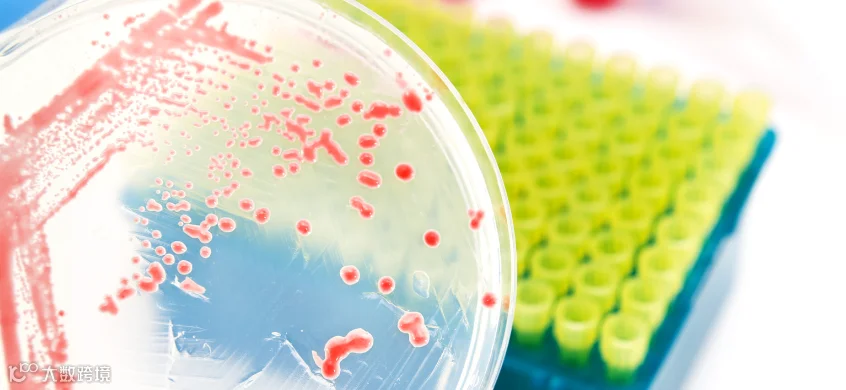

上一期我们介绍了微生物样本采样几种常见方法:4类环境DNA提取样本采集指南 这一期我们介绍6种微生物样本的保存方法。
微生物样本保存是指保持微生物菌株活力和遗传特征的技术。微生物在使用和传代过程中很容易受到污染、变异甚至死亡,往往会导致菌株退化。菌种保存的目的是保持菌种的活力,避免损失,防止外来微生物的污染,尽量减少或防止变异,保持菌种原有的活力和特性。菌种保存的基本原理是使微生物的生命活动进入半永久休眠状态,换句话说,就是将微生物的新陈代谢限制在最低范围内。
实验室常用的保存方法包括甘油保存法、斜面保存法、穿刺保存法、液体石蜡覆盖法、沙漠土壤保存法和冷冻干燥法。
1. 甘油保存法
这种方法适用于菌种 中长期保存,可保存 1 年以上。由于甘油本身很浓稠,难以计量,通常以 1:1 的比例与生理盐水混合,配制成最终浓度为 50%的甘油溶液。使用时,应按 50%甘油:1:1 菌液的比例与菌液混合,使甘油的最终浓度为 20%-30%,甘油浓度过高或过低都不利于菌种保存。将甘油菌种移至-80℃冰箱中长期冷冻。需要使用菌种时,将冷冻管放入 37°C 水浴中快速解冻,直至菌种完全融化,即可取出菌种进行实验。
这种方法适用范围广,操作简单,保存期长,菌种不易发生变异。
2. 斜面保存法
将菌种接种到合适的固体斜面培养基中。细菌充分生长后,将其转移到 4°C 的冰箱中保存。保存时间取决于微生物的类型。一般来说,霉菌、放线菌和孢子形成菌需要每 2-4 个月传代一次,酵母菌每两个月传代一次,细菌最好每月传代一次。需要使用菌种时,可以用接种环从斜面上取少量细菌进行接种。
这种方法的优点是操作简单,使用方便,不需要特殊设备,可以随时检查保存的菌种是否死亡、变异或被外来菌污染。缺点是保存期短,菌种易发生变异,因为培养基的理化性质不是严格恒定的,反复通过会改变微生物的新陈代谢,而且这种方法被外来菌污染的几率较高。
3. 刺穿保存法
准备一管半固体运送培养基,用接种针挑取菌种,从半固体培养基中心垂直刺入,直至接近试管底部,但不要刺穿,然后沿原穿刺线拔出接种针,放入 4℃冰箱保存。此法与斜面保存法一样,需要定期传代。
4. 液体石蜡覆盖保存法
这种方法是斜面保存法的辅助方法。将菌株接种到合适的固体斜面培养基中。细菌充分生长后,注入无菌液体石蜡覆盖整个斜面,然后直立保存在 4 ℃ 冰箱中。液体石蜡可以防止培养基中水分蒸发导致菌株死亡,还可以使菌株与空气隔离,降低菌株的代谢活性,延长保存时间。需要使用菌种时,可以用接种环从斜面上挑取少量菌种。
这种方法的优点是操作简单,不需要特殊设备,不需要经常传代,保存时间较长。缺点是储存时必须直立放置,占用空间较大。
5. 沙漠土壤保存法
将培养好的菌种与无菌的沙漠土壤混合,将细菌吸附在沙漠土壤载体上。干燥后转入 4°C 冰箱保存。使用菌种时,取出几粒沙子即可。
这种方法操作简单,菌种保存时间长。
6. 冷冻干燥法
将菌种冷冻,通过加压升华去除水分。这样可以减少细胞的生理活动,长期保持菌种的存活状态。需要使用菌种时,使用无菌水或培养基重悬细胞,然后将细胞悬浮液转移到固体培养基平板上进行培养。
这种方法适合菌体的长期保存,但相关设备和操作较其他保存方法复杂。
总结
菌种保存的方法很多,但原理大同小异。首先要选择优良纯种。使用微生物的孢子、芽孢和无性体;其次,创造低温、干燥、缺氧等条件,抑制微生物的代谢功能,使其生命活动降到最低水平或进入休眠状态,从而延长菌种的寿命,保存菌种的原形,防止变异。无论采用哪种保存方法,都要求菌种在保存过程中不死亡、不被外来细菌污染、不降解。
声明:部分图源网络,侵权联删整合了网上诸多资料,因此未能一一注明出处。如有侵权,请联系作者删除。如需转载此文章请注明出处。
品牌优势
捷倍斯生物可以提供专业和完善的核酸分离纯化解决方案,有硅胶柱法、磁珠法与溶液直接法的核酸纯化产品,在二代测序的样品前处理方面有着专业的技术与积累,有完善的针对唾液、血液与血浆等样品的保存、运输与高通量核酸纯化等整套的解决方案。 在诊断试剂原料方面,捷倍斯生物可以提供生物染色剂、高端的表面活性剂、显色底物、生物缓冲剂以及酶制剂与其稳定剂等系列产品。

做值交往的人|做值得信赖的产品



